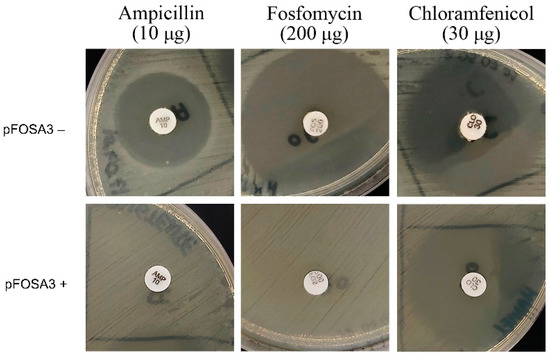

Abstract
Antimicrobial resistance is a public health burden with worldwide impacts and was recently identified as one of the major causes of death in 2019. Fosfomycin is an antibiotic commonly used to treat urinary tract infections, and resistance to it in Enterobacteriaceae is mainly due to the metalloenzyme FosA3 encoded by the fosA3 gene. In this work, we adapted a CRISPR-Cas9 system named pRE-FOSA3 to restore the sensitivity of a fosA3+ Escherichia coli strain. The fosA3+ E. coli strain was generated by transforming synthetic fosA3 into a nonpathogenic E. coli TOP10. To mediate the fosA3 disruption, two guide RNAs (gRNAs) were selected that used conserved regions within the fosA3 sequence of more than 700 fosA3+ E. coli isolates, and the resensitization plasmid pRE-FOSA3 was assembled by cloning the gRNA into pCas9. gRNA_195 exhibited 100% efficiency in resensitizing the bacteria to fosfomycin. Additionally, the edited strain lost the ampicillin resistance encoded in the same plasmid containing the synthetic fosA3 gene, despite not being the CRISPR-Cas9 target, indicating plasmid clearance. The in vitro analysis presented here points to a path that can be explored to assist the development of effective alternative methods of treatment against fosA3+ bacteria.
1. Introduction
Escherichia coli is a Gram-negative bacillus that is a member of the gut microbiota and can be associated with human intestinal and extraintestinal diseases [1,2,3,4]. Among the main subtypes of E. coli, the so-called uropathogenic E. coli (UPECs) are the most relevant in the epidemiological context of uncomplicated urinary tract infections (UTIs), accounting for 80 to 90% of cases, mainly affecting women [5].
Fosfomycin is an antibiotic commonly used to treat UTIs and is analogous to the phosphoenolpyruvate (PEP) produced by different species of the genus Streptomyces [6] and by some strains of Pseudomonas syringae [7]. Its discovery by Hendlin et al. occurred in 1969, when the authors demonstrated its bactericidal activity against Gram-positive and Gram-negative microorganisms. Fosfomycin has a unique mechanism of action that consists of inhibiting the UDP-N-acetylglucosamine enolpyruvyl transferase (MurA) enzyme, which is responsible for the first cytosolic step in bacterial cell-wall synthesis [8].
Fosfomycin resistance occurs due to mutations in the murA gene, recycling of peptidoglycan instead of de novo synthesis of its precursor molecule (UDP-MurNAc), or the production of fosfomycin-inhibiting enzymes called FosA [9]. FosA (glutathione S-transferase) is a metalloenzyme that inactivates fosfomycin by catalyzing the addition of glutathione to the fosfomycin epoxide ring through a nucleophilic attack [10]. Among the various subtypes of plasmid-associated FosA enzymes, FosA3 is the most widespread acquired fosfomycin-modifying enzyme in Enterobacteriaceae [11,12,13,14].
Although antimicrobial resistance (AMR) is a natural phenomenon among microorganisms [15], the continuous and indiscriminate use of antimicrobials aids the selection of resistant microorganisms in a faster and more worrying way [16,17]. Increases in AMR limit the options for treating infections, resulting in yearly increases in the incidence of deaths associated with multidrug-resistant microorganisms [16,18]. This scenario will become progressively more burdensome if alternative treatments for these infections and effective antimicrobial control and stewardship programs are not established.
Recently, several studies have evaluated the ability of the CRISPR-Cas9 system to create antimicrobials that target only resistant bacteria [19,20,21,22]. Thus, when the system’s target develops resistance genes, the CRISPR-Cas9-edited bacteria undergo a resensitization process that reverts their resistant phenotype to its non-resistant form [23]. However, to date, no study has sought to evaluate these methodologies for the resensitization of fosfomycin-resistant bacteria. In this context, we aimed to adapt a system mediated by CRISPR-Cas9, called pRE-FOSA3, for the resensitization of fosfomycin-resistant fosA3+ E. coli.
2. Results
2.1. Analysis of the Occurrence of fosA Genes in Bacteria
We used genotypic data from 88,998 fosA3+ bacterial isolates available in NDARO to analyze the occurrence of fosA3 genes in E. coli isolates. Among them, only 4926 entries corresponded to the E. coli species (5.53%). FosA3 was the main fosA allele found in E. coli, with a relative frequency of 84.38% in Brazil and 45.5% worldwide (Figure 1).

Figure 1.
Occurrence of fosA alleles in Escherichia coli isolates. (a) Worldwide isolates; (b) isolates located in Brazil.
Analysis of multiple sequence alignment revealed that the FosA3 enzyme is highly conserved among several species of clinically relevant Enterobacteriaceae (Figure S1). Based on this, we chose to use fosA3 as the main target for resensitization since the other FosA proteins were not common in E. coli or did not have conserved segments that allowed the design of gRNAs (Figure S2). Furthermore, the data obtained between 2015 and 2020 showed a continuous increase in fosA3+ isolates in terms of both total numbers and E. coli isolates only (Figure S3).
2.2. Generation of a Fosfomycin-Resistant E. coli Strain
To create a fosA3+ fosfomycin-resistant E. coli strain, the fosA3 allele was synthesized and cloned into the pBlueScript II SK (+) vector, generating pFOSA3 (Figure S4). The pFOSA3 vector has two resistance determinants: the ampR gene (ampicillin resistance), which is used as a selection marker, and the fosA3 gene, the target of this study. The pFOSA3 vector was transformed into E. coli TOP10 and subjected to tests to determine the resistance phenotype. The disk diffusion tests showed the absence of inhibition halos for ampicillin and fosfomycin, confirming the fosfomycin-resistant phenotype upon acquisition of the pFOSA3 plasmid (Figure 2).
Figure 2.
Confirmatory disk diffusion of the resistant phenotype of pFOSA3+ E. coli TOP10. Representative photographs of disk diffusion plates obtained in one of the assays.
2.3. pFOSA3+ E. coli Resistance Reversal
The method used in this work allows the expression of gRNAs and the Cas9 enzyme in a single plasmid with a selective marker for chloramphenicol. Thus, gRNAs_195 and 198, which targeted the synthetic fosA3 allele, were individually cloned into pCAS9, which contained the Cas9 enzyme sequence derived from Streptococcus pyogenes, resulting in pRE-FOSA3195 and pRE-FOSA3198. To test the efficiency of gRNAs in reverting the fosfomycin-resistant phenotype of the pFOSA3+ E. coli strain to its non-resistant form, we transformed the bacteria with pRE-FOSA3195 and pRE-FOSA3198 and evaluated the resistance phenotype with disk diffusion assays. The pFOSA3+ strain transformed with pRE-FOSA3195 showed inhibition halos that confirmed resistance to chloramphenicol (0 mm) and sensitivity to ampicillin (24 ± 0.5 mm) and fosfomycin (44 ± 0.5 mm), with a significant difference (p < 0.0001) when compared to the resistant control (pFOSA3+) and CRISPR control (pFOSA3+/pCAS9+) groups (Figure 3, Table 1).

Figure 3.
Disk diffusion test with E. coli grown on Mueller–Hinton agar. (a) Representative photographs of disk diffusion plates obtained in one of the assays showing the presence/absence of inhibition halos. (b) A graph showing the data obtained from the inhibition halos, with fosfomycin disks (μg) supplemented with glucose-6-phosphate; data were obtained in biological and technical replicates; black dots represent individual measurements of the inhibition halos, and asterisks indicates significant difference **** p < 0.0001. Sensitive control: TOP10/pFOSA3--; CRISPR control: TOP10/pFOSA3+/pCAS9+; Resistant control: TOP10/pFOSA3+; gRNA_195: TOP10/pFOSA3+/pRE-FOSA3gRNA_195. The inference was made with an unpaired t-test with Welch correction.

Table 1.
Inhibition-zone diameters for ampicillin, fosfomycin, and chloramphenicol.
In accordance with CLSI guidelines, the bacteria treated with pRE-FOSA3138 remained resistant to fosfomycin and did not generate statistically significant results compared to the sensitive control. However, after an additional 24 h of incubation, pRE-FOSA3138 reverted the resistant phenotype of pFOSA3+ bacteria to the non-resistant phenotype. Furthermore, the bacteria treated with pRE-FOSA3195 had a resensitization efficiency of 100 ± 0%, while the efficiency observed with the bacteria that received pRE-FOSA3198 was 4.74 ± 0.9%. Consequentially, we chose to further investigate the effects only associated with pRE-FOSA3195.
Growth curves for bacteria in the presence or absence of fosfomycin were analyzed to determine the sensitivity to fosfomycin. While the resistant control (pFOSA3+) and CRISPR control (pFOSA3+/pCAS9+) groups showed no significant difference in their growth conditions in the presence of fosfomycin (Figure 4a,b, respectively), the bacteria in the sensitive control group (pFOSA3−) and resensitized group (pFOSA3+/pRE-FOSA3+) (Figure 4c,d, respectively) showed similar sensitivities to each other, with a statistically significant difference (p < 0.0001) associated with the presence or absence of fosfomycin.

Figure 4.
Growth curves for bacteria in medium with or without fosfomycin (supplemented with 25 μg/mL glucose-6-phosphate). (a) Resistant control (pFOSA3+); (b) CRISPR control (pFOSA3+/pCAS9); (c) sensitive control (pFOSA3–); and (d) resensitization group (pFOSA3+/pRE-FOSA3+). G6P: glucose-6-phosphate. Asterisk: statistically significant difference (p < 0.0001); ns: nonsignificant difference. Values represent the mean ± standard deviation of three independent experiments (biological and technical triplicates). The inference was made using an unpaired t-test with Welch correction. p < 0.0001.
These results indicate that the resensitized bacteria underwent a reversal of the resistant phenotype in the presence of the resensitization vector pRE-FOSA3195. The observed reversal corroborates what was previously observed with disk diffusion assays. Furthermore, it is worth noting the similar growth observed in the CRISPR control, which received only Cas9 without gRNA, and the resistant control, which indicates that the Cas9 enzyme did not have a negative effect on bacterial growth even in the presence of fosfomycin.
3. Discussion
Fosfomycin is a relatively old antibiotic often used in clinical practice to treat lower UTIs in women [9,24,25]. Due to its unique chemical structure and low incidence of cross-resistance, fosfomycin has been explored for the treatment of infections caused by multidrug-resistant Enterobacteriaceae [9,24,25]. The main pathogen responsible for most lower UTIs, both in women and men, is E. coli [26,27]. The main form of fosfomycin resistance found in E. coli isolates and other Enterobacteriaceae, such as Salmonella spp. and Shigella spp., occurs through the production of fosfomycin-modifying enzymes belonging to the FosA family. In this study, it was observed that the fosA3 allele was the main subtype found in E. coli isolates (84.38% in Brazil and 45.5% worldwide), similar to what has been shown in previous studies [12,28,29]. Furthermore, the analyses of the isolates deposited in the NDARO database in this study demonstrated that the incidence of fosfomycin resistance in bacteria is more than doubling each year. However, given the SARS-CoV-2 pandemic and the possible reduction in the efficiency of antimicrobial control, monitoring, and stewardship programs, the reported data may be underestimated [30,31,32].
Regarding the sequence of the FosA3 protein, our results showed that it is highly conserved between and within species, similar to what has already been described [12,33], reinforcing the suitability of its selection as a target for strategies involving the reversal of the fosfomycin-resistant phenotype mediated by gene disruption. Another important factor associated with fosA3 is the presence of other determinants in the same mobile element where the fosA3 allele is located. Several recent studies have reported the presence of fosA3 collocated with blaCTX-M alleles and surrounded by two IS26 segments in opposite directions in conjugable plasmids [34,35,36,37,38]. In addition, most reported cases of bacteria producing broad-spectrum beta-lactamases (ESBL) and FosA3 refer to environmental samples, such as food, river water, sewage, and carcasses [38,39]. Another recent study presented evidence of blaCTX-M+ and fosA3+ ESBL-producing E. coli in different samples associated with poultry [40]. These data, taken together, indicate that the presence of bacteria producing FosA3 and ESBL in the community context, serving as reservoirs, may be decisive for the future dissemination of these resistance abilities. Consequentially, strategies to combat fosfomycin resistance are extremely relevant.
The CRISPR-Cas9 system has been demonstrated to effectively promote new opportunities for the eradication of multidrug-resistant strains in vitro by disrupting resistance determinants or vital elements for the replication of the plasmids in which they are found [19,21,22]. Based on this, we investigated the potential of the CRISPR-Cas9 system for combatting AMR mediated by the fosA3 allele present within a commercial high-copy plasmid, pBC-SK II, which was transformed into a nonpathogenic E. coli TOP10 strain. To achieve this, two regions fully conserved in all 716 fosA3+ E. coli isolates, which were present in a relatively early region of the gene, were selected in order to design two gRNAs (gRNA_195 and gRNA_198) for further resensitization assays.
pRE-FOSA3195 was able to completely reverse the resistant phenotype of pFOSA3+ bacteria, similar to what has been achieved with other types of resistance [19,21,22]. Furthermore, pRE-FOSA3195 was more efficient than pRE-FOSA3198. pRE-FOSA3198 was able to resensitize pFOSA3+ bacteria after only two days, approximately, of total incubation time [41]. The CHOP-CHOPv3 prediction program showed that these were the two most efficient gRNAs (Table S1). Additionally, the distance between the two gRNAs is only three nucleotides, and the GC content is 5% higher in gRNA_198. We do not know the reason for such a significant difference in the efficiency of resensitization. However, the importance of investigating two or more gRNAs when intending to use CRISPR-Cas9 is evident, given that the efficiencies calculated by the prediction programs are only estimated and are not necessarily reproduced in in vitro or in vivo assays.
The discrepancy observed may have been associated with the significant variation in the action of the ribonucleoprotein complex (RNP) between different types of target sites or cell lines, involving several factors that can influence the binding and cleavage efficiency of the RNP complex [42,43,44,45,46,47,48,49,50]. Considering this in addition to the fact that most prediction programs, including the one used in this work, base their scores on empirical decisions using different computational methods, these programs should be considered as experimental bases for the selection of sets of gRNAs, allowing their efficiency and the variables in question to be tested in study models [47,50].
Nevertheless, in addition to the reversal of the fosfomycin-resistant phenotype in the bacteria treated with pRE-FOSA3195, we observed the reversal of the ampicillin resistance encoded in the ampR gene collocated on the same plasmid as fosA3 (pFOSA3). This suggests that, after the disruption of fosA3, E. coli TOP10 pFOSA3+ possibly suffered the elimination of the pFOSA3 plasmid, thus losing the determinants of resistance to both fosfomycin and ampicillin. This phenomenon has been described previously [19,21] and can be used as a strategy to increase the efficiency of resensitization or even to reverse the phenotypes of several types of resistance with sequences located on the same plasmid. Although we applied this strategy only to E. coli strains, other studies have explored the same principles with other bacteria species, such as Salmonella enterica, Klebsiella pneumoniae, Enterobacter hormaechei, Enterobacter xiangfangensis, Serratia marcescens [51], and methicillin-resistant Staphylococcus aureus [21]. This indicates that using CRISPR to kill or resensitize bacteria has potential for broad application with different pathogenic microorganisms and resistance determinants. However, it is important to note that the ideal CRISPR target will depend on the characteristics inherent to the microorganism in question, and the technique’s success will also imply a good choice of target and a delivery method suitable for the desired microorganism.
Despite the evident results for the in vitro resensitization of the fosfomycin-resistant bacteria obtained in this work, no tests have been carried out on clinical isolates of fosfomycin-resistant E. coli to date. Thus, to bring more robustness to what has been developed, evaluation of the pRE-FOSA3 system in different sets of fosfomycin-resistant isolates remains a prospective approach that could be used to assess whether this system has the efficiency and replicability necessary for the development of a strategy to combat AMR. Furthermore, despite being an in vitro study, in vivo evaluations and exploration of pRE-FOSA3 delivery strategies would be extremely important to solidify the results obtained in this work. Finally, we hope that the target sequences determined in this study will provide a basis for developing strategies to combat fosA3-mediated fosfomycin resistance.
4. Materials and Methods
4.1. Analysis of the Occurrence of fosA Genes in Bacteria
Analysis of the occurrence of fosA genes in bacteria was performed using data from the National Database of Antibiotic-Resistant Organisms (NDARO). The keywords “fosA” and “fosfomycin resistance” were used to acquire data with the Pathogen Browser search tool. A .csv file containing data on 89,998 isolates of various bacterial species was obtained and analyzed in Python to generate representative graphs of the occurrence of fosA genes in E. coli isolates.
4.2. Analysis of the fosA3 DNA and Protein Sequences
A .csv file with data regarding the nucleotide sequences of the fosA3 allele was obtained with the Pathogen Detection Microbial Browser for Identification of Genetic and Genomic Elements (MicroBIGG-E) from the National Center for Biotechnology Information (NCBI, NIH). The contig identification sequences of each fosA3 gene were used to recover the fosA3 gene sequences from 716 E. coli isolates that showed identities greater than 90% with the reference sequence (WP_014839980.1). The sequences were aligned with MUSCLE in Jalview software [52,53]. The reference FosA sequences are listed in Table S2, and the alignment can be seen in Figure S5.
4.3. Design of gRNAs Targeting fosA3
The alignment of the 716 fosA3 sequences was used to choose fully conserved regions for the design of gRNAs. The prediction of gRNA was performed in the online web server CHOP-CHOPv3 (http://chopchop.cbu.uib.no/) accessed on 27 May 2021 [41] using the consensus sequence of the fosA3 generated in the alignment. The genome of the uropathogenic strain E. coli CF7073 (ASM744v1) was used as a reference for off-target estimation. A .csv file with the results was obtained and filtered to show only gRNA sequences that showed no off-target effects with the reference genome and targeted regions without mutations over a 20 nucleotide span. In all, 61 gRNAs were obtained. Two gRNAs were chosen for the analyses (gRNA_195 and gRNA_198) based on the efficiency score and annealing position provided by CHOP-CHOPv3 (Table S1).
4.4. pRE-FOSA3 Assembly
The pRE-FOSA3 plasmid was constructed based on the pCas9 vector purchased from Addgene (#42876). gRNAs 195 and 198, targeting fosA3, were commercially synthesized (Exxtend, SP, BR) and cloned into the pCas9 vector, adapting the BsaI enzyme protocol [54]. At the end of the cloning, two vectors expressing Cas9 and gRNA_195 (pRE-FOSA3195) or gRNA_198 (pRE-FOSA3198) were obtained.
4.5. Generation of an E. coli Fosfomycin-Resistant Strain
To construct a fosfomycin-resistant strain of E. coli, the fosA3 gene was synthesized (FastBio, São Paulo, Brazil) in the pBlueScript II SK (+) vector using a cloning strategy with BamHI and HindIII. The product of this cloning was a vector that expressed the fosA3 gene constitutively, with a selection marker for ampicillin (ampR) named pFOSA3 (Figure S4). pFOSA3 was transformed by heat shock into chemically competent E. coli TOP10. Then, the transformed cells were plated on LB agar containing 100 μg/mL ampicillin. The plate was incubated at 37 °C overnight. To confirm the fosfomycin-resistant phenotype, disk diffusion assays were performed.
4.6. Resensitization of E. coli pFOSA3+ with pRE-FOSA3
To deliver pRE-FOSA3 vectors to E. coli pFOSA3+ by heat shock, approximately 100 ng of each vector (pRE-FOSA3gRNA_195 or pRE-FOSA3gRNA_198) was added separately to tubes containing chemically competent pFOSA3+ cells. Cells were recovered in lysogeny broth (LB) without antibiotics at a dilution of 1:10 over 1 h at 37 °C and under agitation at 200 rpm. Afterward, 100 μL of the contents of each tube was plated on two LB plates under different conditions: (1) nonselective plate—LB + chloramphenicol (34 μg/mL); (2) selective plate—chloramphenicol (34 μg/mL) + glucose-6-phosphate (25 μg/mL) + fosfomycin (40 μg/mL). As a sensitive control, an isolated colony of E. coli TOP10 was submitted to the same procedures described above, except for pRE-FOSA3 delivery. Resensitization efficiency was calculated as follows: (1—number of colonies on the selective plate/number of colonies on the nonselective plate × 100%).
4.7. Disk Diffusion
The fosfomycin-resistant phenotype of fosA3+ E. coli was determined using fosfomycin disks (200 μg) supplemented with glucose-6-phosphate (50 μg). Ampicillin disks (10 μg) were used to determine the presence of pFOSA3. After resensitization, the resistance phenotype was assessed using disks of fosfomycin (200 μg) supplemented with glucose-6-phosphate (25 μg), ampicillin (10 μg), and chloramphenicol (30 μg) with the colonies isolated from the nonselective plates (LB + 34 μg/mL chloramphenicol). These disk diffusion assays were performed in technical duplicates, and the entire experiment was repeated three times to account for the biological replicates in accordance with CLSI guidelines.
4.8. Growth Curve
Three preinocula were produced using colonies isolated from the nonselective plates of each group in LB with or without antibiotics as follows: (1) E. coli pFOSA3+—ampicillin (100 μg/mL); (2) E. coli pFOSA3+/pCAS9+—ampicillin (100 μg/mL) and chloramphenicol (34 μg/mL); (3) E. coli pFOSA3+/pRE-FOSA3+—chloramphenicol (34 μg/mL); and (4) E. coli TOP10 (pFOSA3–)—no antibiotics. Each preinoculum was incubated at 37 °C with shaking at 200 rpm overnight. The following day, they were adjusted to 0.5 McFarland standard, and 75 μL of each adjusted preinoculum was added to a 96-well microplate containing LB with or without fosfomycin (40 μg/mL) + glucose-6-phosphate (25 μg/mL). Growth kinetics were recorded every hour for 24 h. Each assay was performed in technical triplicate, and the entire experiment was repeated three times for the biological replicates.
4.9. Statistical Analysis
Statistical analyses were assessed using GraphPad Prism software (version 9, GraphPad Software, California, United States) and Python 3.8.8. For both the resensitization and disk diffusion assays, the inference of the significance was made using an unpaired t-test with Welch correction.
Supplementary Materials
The following supporting information can be downloaded at: https://www.mdpi.com/article/10.3390/ijms23169175/s1.
Author Contributions
H.S.M.W.: methodology, validation, writing—original draft preparation; A.R.C.L.: methodology; F.F.T.: investigation, interpretation; L.C.S.M.: methodology, conceptualization, writing—original draft preparation, supervision; H.F.: conceptualization, project administration, funding acquisition, writing—original draft preparation. All authors have read and agreed to the published version of the manuscript.
Funding
This research was funded by the National Council for Scientific and Technological Development (CNPq), CAPES, and Fiocruz. CNPq grant number 424410/2018-4; InovaFiocruz/Fundacão Oswaldo Cruz grant number VPPCB- 07-FIO-18-2-38.
Data Availability Statement
Not applicable.
Acknowledgments
The authors thank the Carlos Chagas Institute, Fiocruz Paraná, and the postgraduate program in Biosciences and Biotechnology of the Carlos Chagas Institute for their support.
Conflicts of Interest
The authors declare no conflict of interest. The funders had no role in the design of the study; in the collection, analyses, or interpretation of data; in the writing of the manuscript, or in the decision to publish the results.
References
- McCue, J.D. Gram-negative bacillary bacteremia in the elderly: Incidence, ecology, etiology, and mortality. J. Am. Geriatr. Soc. 1987, 35, 213–218. [Google Scholar] [CrossRef] [PubMed]
- Mylotte, J.M.; Tayara, A.; Goodnough, S. Epidemiology of bloodstream infection in nursing home residents: Evaluation in a large cohort from multiple homes. Clin. Infect. Dis. 2002, 35, 1484–1490. [Google Scholar] [CrossRef] [PubMed]
- Jain, S.; Self, W.H.; Wunderink, R.G.; Fakhran, S.; Balk, R.; Bramley, A.M.; Reed, C.; Grijalva, C.G.; Anderson, E.J.; Courtney, D.M.; et al. CDC EPIC Study Team Community-Acquired Pneumonia Requiring Hospitalization among U.S. Adults. N. Engl. J. Med. 2015, 373, 415–427. [Google Scholar] [CrossRef] [PubMed]
- Mueller, M.; Tainter, C.R. Escherichia Coli. In StatPearls; StatPearls Publishing: Treasure Island, FL, USA, 2022. [Google Scholar]
- Terlizzi, M.E.; Gribaudo, G.; Maffei, M.E. UroPathogenic Escherichia coli (UPEC) Infections: Virulence Factors, Bladder Responses, Antibiotic, and Non-antibiotic Antimicrobial Strategies. Front. Microbiol. 2017, 8, 1566. [Google Scholar] [CrossRef] [PubMed]
- Hendlin, D.; Stapley, E.O.; Jackson, M.; Wallick, H.; Miller, A.K.; Wolf, F.J.; Miller, T.W.; Chaiet, L.; Kahan, F.M.; Foltz, E.L.; et al. Phosphonomycin, a new antibiotic produced by strains of streptomyces. Science 1969, 166, 122–123. [Google Scholar] [CrossRef]
- Shoji, J.; Kato, T.; Hinoo, H.; Hattori, T.; Hirooka, K.; Matsumoto, K.; Tanimoto, T.; Kondo, E. Production of fosfomycin (phosphonomycin) by Pseudomonas syringae. J. Antibiot. 1986, 39, 1011–1012. [Google Scholar] [CrossRef] [PubMed]
- Skarzynski, T.; Mistry, A.; Wonacott, A.; Hutchinson, S.E.; Kelly, V.A.; Duncan, K. Structure of UDP-N-acetylglucosamine enolpyruvyl transferase, an enzyme essential for the synthesis of bacterial peptidoglycan, complexed with substrate UDP-N-acetylglucosamine and the drug fosfomycin. Structure 1996, 4, 1465–1474. [Google Scholar] [CrossRef]
- Silver, L.L. Fosfomycin: Mechanism and resistance. Cold Spring Harb. Perspect. Med. 2017, 7, a025new262. [Google Scholar] [CrossRef] [PubMed]
- Castañeda-García, A.; Blázquez, J.; Rodríguez-Rojas, A. Molecular mechanisms and clinical impact of acquired and intrinsic fosfomycin resistance. Antibiotics 2013, 2, 217–236. [Google Scholar] [CrossRef]
- Ito, R.; Mustapha, M.M.; Tomich, A.D.; Callaghan, J.D.; McElheny, C.L.; Mettus, R.T.; Shanks, R.M.Q.; Sluis-Cremer, N.; Doi, Y. Widespread Fosfomycin Resistance in Gram-Negative Bacteria Attributable to the Chromosomal fosA Gene. MBio 2017, 8, e00749-17. [Google Scholar] [CrossRef]
- Ito, R.; Pacey, M.P.; Mettus, R.T.; Sluis-Cremer, N.; Doi, Y. Origin of the plasmid-mediated fosfomycin resistance gene fosA3. J. Antimicrob. Chemother. 2018, 73, 373–376. [Google Scholar] [CrossRef] [PubMed]
- Loras, C.; Mendes, A.C.; Peixe, L.; Novais, Â.; Alós, J.-I. Escherichia coli resistant to fosfomycin from urinary tract infections: Detection of the fosA3 gene in Spain. J. Glob. Antimicrob. Resist. 2020, 21, 414–416. [Google Scholar] [CrossRef] [PubMed]
- Cheng, K.; Fang, L.-X.; Ge, Q.-W.; Wang, D.; He, B.; Lu, J.-Q.; Zhong, Z.-X.; Wang, X.-R.; Yu, Y.; Lian, X.-L.; et al. Emergence of fosA3 and blaCTX-M-14 in Multidrug-Resistant Citrobacter freundii Isolates From Flowers and the Retail Environment in China. Front. Microbiol. 2021, 12, 586504. [Google Scholar] [CrossRef] [PubMed]
- Munita, J.M.; Arias, C.A. Mechanisms of antibiotic resistance. Microbiol. Spectr. 2016, 4, 15. [Google Scholar] [CrossRef] [PubMed]
- Llor, C.; Bjerrum, L. Antimicrobial resistance: Risk associated with antibiotic overuse and initiatives to reduce the problem. Ther. Adv. Drug Saf. 2014, 5, 229–241. [Google Scholar] [CrossRef]
- Ventola, C.L. The antibiotic resistance crisis: Part 1: Causes and threats. Pharm. Ther. 2015, 40, 277–283. [Google Scholar]
- O’Neill, J. Tackling drug-resistant infections globally: Final report and recommendations. J. Am. Geriatr. Soc. 2016, 35, 213–218. [Google Scholar]
- Kim, J.-S.; Cho, D.-H.; Park, M.; Chung, W.-J.; Shin, D.; Ko, K.S.; Kweon, D.-H. CRISPR/Cas9-Mediated Re-Sensitization of Antibiotic-Resistant Escherichia coli Harboring Extended-Spectrum β-Lactamases. J. Microbiol. Biotechnol. 2016, 26, 394–401. [Google Scholar] [CrossRef]
- Shabbir, M.A.B.; Shabbir, M.Z.; Wu, Q.; Mahmood, S.; Sajid, A.; Maan, M.K.; Ahmed, S.; Naveed, U.; Hao, H.; Yuan, Z. CRISPR-cas system: Biological function in microbes and its use to treat antimicrobial resistant pathogens. Ann. Clin. Microbiol. Antimicrob. 2019, 18, 21. [Google Scholar] [CrossRef]
- Hao, M.; He, Y.; Zhang, H.; Liao, X.-P.; Liu, Y.-H.; Sun, J.; Du, H.; Kreiswirth, B.N.; Chen, L. CRISPR-Cas9-Mediated Carbapenemase Gene and Plasmid Curing in Carbapenem-Resistant Enterobacteriaceae. Antimicrob. Agents Chemother. 2020, 64, e00843-20. [Google Scholar] [CrossRef]
- Tagliaferri, T.L.; Guimarães, N.R.; Pereira, M. de P.M.; Vilela, L.F.F.; Horz, H.-P.; Dos Santos, S.G.; de Oliveira Mendes, T.A. Exploring the Potential of CRISPR-Cas9 Under Challenging Conditions: Facing High-Copy Plasmids and Counteracting Beta-Lactam Resistance in Clinical Strains of Enterobacteriaceae. Front. Microbiol. 2020, 11, 578. [Google Scholar] [CrossRef] [PubMed]
- Li, Y.; Peng, N. Endogenous CRISPR-Cas System-Based Genome Editing and Antimicrobials: Review and Prospects. Front. Microbiol. 2019, 10, 2471. [Google Scholar] [CrossRef] [PubMed]
- Falagas, M.E.; Vouloumanou, E.K.; Samonis, G.; Vardakas, K.Z. Fosfomycin. Clin. Microbiol. Rev. 2016, 29, 321–347. [Google Scholar] [CrossRef] [PubMed]
- Aghamali, M.; Sedighi, M.; Zahedi Bialvaei, A.; Mohammadzadeh, N.; Abbasian, S.; Ghafouri, Z.; Kouhsari, E. Fosfomycin: Mechanisms and the increasing prevalence of resistance. J. Med. Microbiol. 2019, 68, 11–25. [Google Scholar] [CrossRef] [PubMed]
- Foxman, B. The epidemiology of urinary tract infection. Nat. Rev. Urol. 2010, 7, 653–660. [Google Scholar] [CrossRef]
- Antinori, S.; Pezzani, M.D. Uncomplicated and complicated urinary tract infections in adults: The infectious diseases’s specialist perspective. In Imaging and Intervention in Urinary Tract Infections and Urosepsis; Tonolini, M., Ed.; Springer International Publishing: Cham, Switzerland, 2018; pp. 17–33. ISBN 978-3-319-68275-4. [Google Scholar]
- Jiang, W.; Men, S.; Kong, L.; Ma, S.; Yang, Y.; Wang, Y.; Yuan, Q.; Cheng, G.; Zou, W.; Wang, H. Prevalence of Plasmid-Mediated Fosfomycin Resistance Gene fosA3 Among CTX-M-Producing Escherichia coli Isolates from Chickens in China. Foodborne Pathog. Dis. 2017, 14, 210–218. [Google Scholar] [CrossRef]
- Zurfluh, K.; Treier, A.; Schmitt, K.; Stephan, R. Mobile fosfomycin resistance genes in Enterobacteriaceae-An increasing threat. Microbiologyopen 2020, 9, e1135. [Google Scholar] [CrossRef]
- Khor, W.P.; Olaoye, O.; D’Arcy, N.; Krockow, E.M.; Elshenawy, R.A.; Rutter, V.; Ashiru-Oredope, D. The Need for Ongoing Antimicrobial Stewardship during the COVID-19 Pandemic and Actionable Recommendations. Antibiotics 2020, 9, 904. [Google Scholar] [CrossRef]
- Ashiru-Oredope, D.; Kerr, F.; Hughes, S.; Urch, J.; Lanzman, M.; Yau, T.; Cockburn, A.; Patel, R.; Sheikh, A.; Gormley, C.; et al. Assessing the Impact of COVID-19 on Antimicrobial Stewardship Activities/Programs in the United Kingdom. Antibiotics 2021, 10, 110. [Google Scholar] [CrossRef]
- Ghosh, S.; Bornman, C.; Zafer, M.M. Antimicrobial Resistance Threats in the emerging COVID-19 pandemic: Where do we stand? J. Infect. Public Health 2021, 14, 555–560. [Google Scholar] [CrossRef]
- Yang, T.-Y.; Lu, P.-L.; Tseng, S.-P. Update on fosfomycin-modified genes in Enterobacteriaceae. J. Microbiol. Immunol. Infect. 2019, 52, 9–21. [Google Scholar] [CrossRef] [PubMed]
- Cao, X.L.; Shen, H.; Xu, Y.Y.; Xu, X.J.; Zhang, Z.F.; Cheng, L.; Chen, J.H.; Arakawa, Y. High prevalence of fosfomycin resistance gene fosA3 in bla CTX-M-harbouring Escherichia coli from urine in a Chinese tertiary hospital during 2010-2014. Epidemiol. Infect. 2017, 145, 818–824. [Google Scholar] [CrossRef] [PubMed]
- Cyoia, P.S.; Koga, V.L.; Nishio, E.K.; Houle, S.; Dozois, C.M.; de Brito, K.C.T.; de Brito, B.G.; Nakazato, G.; Kobayashi, R.K.T. Distribution of ExPEC Virulence Factors, blaCTX-M, fosA3, and mcr-1 in Escherichia coli Isolated From Commercialized Chicken Carcasses. Front. Microbiol. 2018, 9, 3254. [Google Scholar] [CrossRef] [PubMed]
- Fernandes, M.R.; Sellera, F.P.; Moura, Q.; Souza, T.A.; Lincopan, N. Draft genome sequence of a CTX-M-8, CTX-M-55 and FosA3 co-producing Escherichia coli ST117/B2 isolated from an asymptomatic carrier. J. Glob. Antimicrob. Resist. 2018, 12, 183–184. [Google Scholar] [CrossRef]
- Lv, L.; Huang, X.; Wang, J.; Huang, Y.; Gao, X.; Liu, Y.; Zhou, Q.; Zhang, Q.; Yang, J.; Guo, J.-Y.; et al. Multiple Plasmid Vectors Mediate the Spread of fosA3 in Extended-Spectrum-β-Lactamase-Producing Enterobacterales Isolates from Retail Vegetables in China. mSphere 2020, 5, e00507-20. [Google Scholar] [CrossRef]
- Biggel, M.; Zurfluh, K.; Treier, A.; Nüesch-Inderbinen, M.; Stephan, R. Characteristics of fosA-carrying plasmids in E. coli and Klebsiella spp. isolates originating from food and environmental samples. J. Antimicrob. Chemother. 2021, 76, 2004–2011. [Google Scholar] [CrossRef]
- Han, L.; Lu, X.-Q.; Liu, X.-W.; Liao, M.-N.; Sun, R.-Y.; Xie, Y.; Liao, X.-P.; Liu, Y.-H.; Sun, J.; Zhang, R.-M. Molecular Epidemiology of Fosfomycin Resistant E. coli from a Pigeon Farm in China. Antibiotics 2021, 10, 777. [Google Scholar] [CrossRef]
- de Souza, G.L.E.; Medeiros, L.P.; Dibo, M.; Nishio, E.K.; Koga, V.L.; Gonçalves, B.C.; Grassotti, T.T.; de Camargo, T.C.L.; Pinheiro, J.J.; Vespero, E.C.; et al. Detection of ESBL/AmpC-Producing and Fosfomycin-Resistant Escherichia coli From Different Sources in Poultry Production in Southern Brazil. Front. Microbiol. 2020, 11, 604544. [Google Scholar] [CrossRef]
- Labun, K.; Montague, T.G.; Krause, M.; Torres Cleuren, Y.N.; Tjeldnes, H.; Valen, E. CHOPCHOP v3: Expanding the CRISPR web toolbox beyond genome editing. Nucleic Acids Res. 2019, 47, W171–W174. [Google Scholar] [CrossRef]
- Fu, Y.; Foden, J.A.; Khayter, C.; Maeder, M.L.; Reyon, D.; Joung, J.K.; Sander, J.D. High-frequency off-target mutagenesis induced by CRISPR-Cas nucleases in human cells. Nat. Biotechnol. 2013, 31, 822–826. [Google Scholar] [CrossRef]
- Fu, Y.; Sander, J.D.; Reyon, D.; Cascio, V.M.; Joung, J.K. Improving CRISPR-Cas nuclease specificity using truncated guide RNAs. Nat. Biotechnol. 2014, 32, 279–284. [Google Scholar] [CrossRef] [PubMed]
- Koike-Yusa, H.; Li, Y.; Tan, E.-P.; Velasco-Herrera, M.D.C.; Yusa, K. Genome-wide recessive genetic screening in mammalian cells with a lentiviral CRISPR-guide RNA library. Nat. Biotechnol. 2014, 32, 267–273. [Google Scholar] [CrossRef] [PubMed]
- Chari, R.; Mali, P.; Moosburner, M.; Church, G.M. Unraveling CRISPR-Cas9 genome engineering parameters via a library-on-library approach. Nat. Methods 2015, 12, 823–826. [Google Scholar] [CrossRef] [PubMed]
- Moreno-Mateos, M.A.; Vejnar, C.E.; Beaudoin, J.-D.; Fernandez, J.P.; Mis, E.K.; Khokha, M.K.; Giraldez, A.J. CRISPRscan: Designing highly efficient sgRNAs for CRISPR-Cas9 targeting in vivo. Nat. Methods 2015, 12, 982–988. [Google Scholar] [CrossRef]
- Chuai, G.-H.; Wang, Q.-L.; Liu, Q. In silico meets in vivo: Towards computational CRISPR-based sgRNA design. Trends Biotechnol. 2017, 35, 12–21. [Google Scholar] [CrossRef]
- You, Q.; Zhong, Z.; Ren, Q.; Hassan, F.; Zhang, Y.; Zhang, T. CRISPRMatch: An Automatic Calculation and Visualization Tool for High-throughput CRISPR Genome-editing Data Analysis. Int. J. Biol. Sci. 2018, 14, 858–862. [Google Scholar] [CrossRef]
- Ren, Q.; Zhong, Z.; Wang, Y.; You, Q.; Li, Q.; Yuan, M.; He, Y.; Qi, C.; Tang, X.; Zheng, X.; et al. Bidirectional Promoter-Based CRISPR-Cas9 Systems for Plant Genome Editing. Front. Plant Sci. 2019, 10, 1173. [Google Scholar] [CrossRef]
- Liu, G.; Zhang, Y.; Zhang, T. Computational approaches for effective CRISPR guide RNA design and evaluation. Comput. Struct. Biotechnol. J. 2020, 18, 35–44. [Google Scholar] [CrossRef]
- Bikard, D.; Euler, C.W.; Jiang, W.; Nussenzweig, P.M.; Goldberg, G.W.; Duportet, X.; Fischetti, V.A.; Marraffini, L.A. Exploiting CRISPR-Cas nucleases to produce sequence-specific antimicrobials. Nat. Biotechnol. 2014, 32, 1146–1150. [Google Scholar] [CrossRef]
- Edgar, R.C. MUSCLE: Multiple sequence alignment with high accuracy and high throughput. Nucleic Acids Res. 2004, 32, 1792–1797. [Google Scholar] [CrossRef]
- Waterhouse, A.M.; Procter, J.B.; Martin, D.M.A.; Clamp, M.; Barton, G.J. Jalview Version 2—A multiple sequence alignment editor and analysis workbench. Bioinformatics 2009, 25, 1189–1191. [Google Scholar] [CrossRef] [PubMed]
- Jiang, W.; Bikard, D.; Cox, D.; Zhang, F.; Marraffini, L.A. RNA-guided editing of bacterial genomes using CRISPR-Cas systems. Nat. Biotechnol. 2013, 31, 233–239. [Google Scholar] [CrossRef] [PubMed]
Publisher’s Note: MDPI stays neutral with regard to jurisdictional claims in published maps and institutional affiliations. |
© 2022 by the authors. Licensee MDPI, Basel, Switzerland. This article is an open access article distributed under the terms and conditions of the Creative Commons Attribution (CC BY) license (https://creativecommons.org/licenses/by/4.0/).